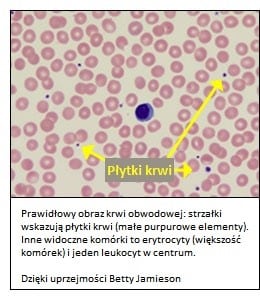

W skrócie
W jakim celu badanie jest wykonywane?
Badanie liczby płytek wykonuje się w celu oceny zmian liczby krwinek płytkowych w ramach rutynowych badań kontrolnych; wykorzystywane jest do wykrywania, rozpoznawania i monitorowania zaburzeń i chorób, które mają wpływ na liczbę płytek krwi. Badanie umożliwia rozpoznawanie zarówno zaburzeń, w których liczba płytek krwi jest zbyt mała (mamy wtedy do czynienia z małopłytkowością lub trombocytopenią), jak i zbyt duża (stan określany jako nadpłytkowość lub trombocytoza).
Kiedy badanie jest wykonywane?
Badanie stanowi część badania morfologii krwi, tj. rutynowego badania często wykonywanego w ramach ogólnej oceny stanu zdrowia. W szczególności, badanie wykonywane jest u osób z epizodami krwawień z nieznanych przyczyn, z wydłużonym czasem krwawienia lub z powodu innych objawów wskazujących na możliwość zaburzeń dotyczących płytek krwi.
Jak się pobiera próbkę do badania?
Próbka krwi pobrana z żyły łokciowej z dodatkiem czynników zapobiegających krzepnięciu krwi.
Pobranie próbki wymaga nakłucia igłą żyły łokciowej lub nakłucia opuszki palca (dorośli i dzieci) lub pięty (noworodki).
Czy do badania trzeba się przygotować?
Nie.
Informacja o próbce
Co się oznacza?
Płytki krwi (trombocyty) to maleńkie fragmenty cytoplazmy bardzo dużych komórek nazywanych megakariocytami. Płytki krwi powstają z megakariocytów w szpiku kostnym oraz w niewielkiej liczbie w płucach i są uwalniane do krwi krążącej. Są niezbędne do prawidłowego krzepnięcia krwi. Badanie służy do sprawdzenia czy liczba płytek we krwi pacjenta jest prawidłowa.
W razie uszkodzenia naczynia krwionośnego płytki krwi pomagają zatrzymać krwawienie dzięki: przyleganiu do miejsca zranienia, agregacji (zlepianiu się) z innymi płytkami, uwalniania substancji stymulujących dalszą agregację innych płytek krwi. Te reakcje prowadzą do powstania luźnego czopu płytkowego – proces ten nazywamy hemostazą pierwotną. Równocześnie płytki wspomagają kaskadę krzepnięcia, która polega na aktywacji czynników krzepnięcia w odpowiedniej kolejności. Proces ten, zwany hemostazą wtórną, prowadzi do powstania włókien fibryny wplecionych w luźny czop płytkowy, które łączą się następnie w sieć fibryny i obkurczają, aby utworzyć stabilny czop hemostatyczny, który pozostaje w uszkodzonym miejscu do czasu wygojenia zranienia. Kiedy nie jest już potrzebny, inne czynniki rozpuszczają go i usuwają.
Aby krzepnięcie przebiegało prawidłowo każda ze składowych procesu hemostazy pierwotnej i wtórnej musi być obecna, aktywowana w odpowiednim czasie i działać we właściwy sposób.
Trombocyty żyją w krążeniu około 8-10 dni, więc szpik kostny musi stale wytwarzać nowe krwinki, aby zastąpić te zniszczone, zużyte i/lub utracone zarówno z powodu mikrourazów, jak i krwawień z powodu poważniejszych uszkodzeń ciała.
U osoby dorosłej prawidłowa liczba płytek wynosi około 150 000 do 450 000 w mm3 (µl) krwi. Jeśli płytek jest zbyt mało albo nie spełniają którejkolwiek ze swych funkcji, czop hemostatyczny może nie powstać i pacjent narażony jest na ryzyko nadmiernych krwawień. Również zbyt wysoka liczba płytek jest niebezpieczna, gdyż może prowadzić do nadmiernego wykrzepiania krwi (zakrzepicy).
Badanie
W jakich przypadkach badanie jest wykonywane?
Badanie może być wykorzystane do wykrywania wielu chorób, które wpływają na liczbę płytek krwi. Może być częścią badań diagnostycznych przeprowadzanych m.in. u chorych z zaburzeniami krzepnięcia, chorobami szpiku kostnego lub nadkrzepliwością.
Może stanowić narzędzie do monitorowania przebiegu choroby, będącej przyczyną zaburzeń lub monitorowania skuteczności jej leczenia.
Badanie liczby płytek krwi można połączyć z badaniem czynności płytek krwi oraz badaniami układu krzepnięcia, takimi jak PT i aPTT. Jeśli wyniki tych badań są nieprawidłowe wyjaśnienie przyczyny zaburzeń wymaga wykonania dodatkowych badań, jak np. oznaczenie przeciwciał przeciwjądrowych (ANA) i antyfosfolipidowych, stężenie witaminy B12, kwasu foliowego oraz testy w kierunku wykrycia wirusa WZW typu B i/lub C oraz badanie szpiku kostnego.
W jakich przypadkach badanie jest zlecane?
Oznaczenie liczby płytek krwi często zlecane jest jako część standardowej morfologii krwi, która jest badaniem wykonywanym często w ramach badań okresowych.
Prawie zawsze zleca się to badanie w przypadku, gdy u pacjenta występują objawy związane z niską liczbą płytek krwi lub zaburzenia krzepnięcia, takie jak:
- siniaki niewiadomego pochodzenia lub powstające przy niewielkim nacisku
- przedłużające się krwawienia nawet z małego skaleczenia
- powtarzające się krwawienia z nosa
- krwawienia z przewodu pokarmowego (krew można wykryć w kale)
- bardzo obfite krwawienia miesięczne
- małe czerwone punkty na skórze (petechie), czasem wyglądające jak wysypka
- małe brunatnoczerwone plamy na skórze (purpura) spowodowane wylewami podskórnymi (plamica).
Badanie wykonuje się także u osób z podejrzeniem zwiększonej liczby płytek krwi. Nadpłytkowość może spowodować nadmierne wykrzepianie lub niekiedy krwawienia, jeśli czynność płytek nie jest prawidłowa. Jednak u większości osób nadpłytkowość jest bezobjawowa i można ją wykryć tylko wykonując badanie morfologii krwi w ramach badań okresowych lub z innych powodów.
Co oznacza wynik?
Małopłytkowość i jej przyczyny
Jeżeli liczba płytek spada poniżej 50 000/µl może dochodzić do łagodnych krwawień, zwłaszcza przy współwystępujących chorobach (np. nerek). Przy liczbie płytek poniżej 20 000/µl, wystąpić może samoistne krwawienie, nawet stanowiące zagrożenie dla życia. Osobom ze znacznym niedoborem płytek krwi można pomóc podejmując odpowiednie leczenie lub przetaczając koncentraty krwinek płytkowych.
Małopłytkowość może rozwinąć się nagle (ostra trombocytopenia), może być tymczasowa lub może rozwijać się przez dłuższy okres czasu (małopłytkowość przewlekła).
Małopłytkowość może być spowodowana wieloma różnymi zaburzeniami lub chorobami, najczęściej nabytymi, jednak w rzadkich przypadkach może być również uwarunkowana genetycznie.
Nabyte przyczyny małopłytkowości można ogólnie podzielić na dwie grupy:
- zaburzenia czynności szpiku, który nie wytwarza płytek w dostatecznej liczbie
- zaburzenia, w których płytki są produkowane w prawidłowych ilościach, lecz są zużywane lub niszczone szybciej niż normalnie.
Stany, którym towarzyszy niska liczba płytek z powodu niedostatecznego wytwarzania:
- Białaczki, chłoniaki lub inne nowotwory wywodzące się ze szpiku kostnego lub przebiegające z jego zajęciem. Wypieranie prawidłowych komórek ze szpiku przez komórki nowotworowe powoduje zmniejszoną liczbę megakariocytów i zmniejszenie możliwości wytwarzania trombocytów. Znaczne obniżenie liczby płytek krwi u chorych na białaczkę często prowadzi do obfitych krwawień.
- Zespół mielodysplastyczny – schorzenie często będące stanem przedbiałaczkowym, w którym dochodzi do dysfunkcji szpiku kostnego w zakresie wytwarzania komórek prekursorowych jednej lub więcej linii komórkowych
- Niedokrwistość aplastyczna – schorzenie, w którym zmniejsza się wytwarzanie przez szpik wszystkich komórek
- Chemioterapia i radioterapia, które mogą prowadzić do uszkodzenia szpiku kostnego
- Uszkodzenie szpiku kostnego przez różne związki chemiczne (w tym benzen, rozpuszczalniki organiczne, pestycydy)
- Zapalenie szpiku kostnego, najczęściej gronkowcowe
- Niedobór witaminy B12 i kwasu foliowego, który oprócz niedokrwistości megaloblastycznej wpływa również na obniżenie liczby płytek
- W marskości wątroby upośledzona jest produkcja wszystkich białek, w tym trombopoetyny, która stymuluje megakariocyty do dojrzewania i produkcji płytek w szpiku kostnym
- Długotrwałe krwawienia (np. przewlekłe krwawienia z wrzodów żołądka)
Przyczyny trombocytopenii jako następstwa nadmiernego zużycia lub niszczenia płytek:
- Zakażenia wirusami EBV, HPV, HIV lub wirusem odry
- Przyjmowanie niektórych leków, w tym acetaminofenu, chinidyny, sulfonamidów, digoksyny, wankomycyny, walium, nitrogliceryny
- Zwiększone zużycie płytek krwi występuje w wielu chorobach, np. w zespole rozsianego krzepnięcia wewnątrznaczyniowego (DIC), zakrzepowej plamicy małopłytkowej (TTP) i zespole hemolityczno-mocznicowym (HUS). Często są to stany ostre, potencjalnie zagrażające życiu, w których dochodzi do niszczenia również erytrocytów.
- Sepsa, szczególnie wywołana zakażeniem bakteriami Gram ujemnymi (np. Escherichia coli)
- Pierwotna małopłytkowość immunologiczna (ITP), w której układ odpornościowy zaczyna wytwarzać przeciwciała przeciwko własnym płytkom, jest jedną z częstszych przyczyn małopłytkowości przy braku innych zaburzeń. U dzieci często jest skutkiem przebycia infekcji wirusowej i stan ten ulega samoistnej normalizacji bez jakiegokolwiek leczenia. U dorosłych jest kojarzona ze stanem przewlekłym.
- Choroby autoimmunologiczne, takie jak toczeń, czy reumatoidalne zapalenie stawów, w których organizm wytwarza przeciwciała niszczące własne narządy i tkanki.
- Trombocytopenia indukowana heparyną (HIT) u pacjentów, którzy przeszli lub są w trakcie terapii heparyną, zwłaszcza niefrakcjonowaną.
- U około 10% kobiet podczas ciąży, liczba płytek może być niższa, najczęściej między 100000 a 150000/µl. Obniżenie liczby płytek może być też obserwowane przed menstruacją.
- Fizyczne uszkodzenie płytek przez wszczepione sztuczne zastawki lub bypassy
Małopłytkowość uwarunkowana genetycznie:
Występuje w przebiegu rzadkich chorób wrodzonych:
- Zespół Wiskotta-Aldricha – choroba przebiegająca z niedoborem odporności; na skutek mutacji genu WAS dochodzi do zaburzenia dojrzewania limfocytów, makrofagów oraz megakariocytów (dziedziczenie sprzężone z chromosomem X)
- Anomalia May-Hegglina – na skutek mutacji w genie MYH9 powstają wielkie płytki o nieprawidłowym kształcie, co przyczynia się do ich przyspieszonego rozpadu (dziedziczenie autosomalne dominujące)
- Choroba Gauchera – jedna z chorób spichrzeniowych, w której na skutek mutacji genu GBA dochodzi do upośledzenia rozkładu glikolipidów (glukozyloceramidu) i ich odkładania się w wątrobie, śledzionie, kościach doprowadzając do dysfunkcji tych organów i w konsekwencji do małopłytkowości (dziedziczona autosomalnie recesywnie)
- Zespół Chediaka-Higashiego – choroba przebiegająca z niedoborem odporności, zaburzeniem pęcherzykowego transportu wewnątrzkomórkowego, na skutek mutacji w genie LYST (dziedziczenie autosomalne recesywne)
- Trombastenia Glanzmanna – choroba, u podłoża której leży mutacja genów kodujących kompleks glikoproteinowy GPIIb/IIIa występujący na powierzchni błony płytek, który stanowi receptor dla czynników krzepnięcia, np. fibrynogenu, czynnika von Willebranda (dziedziczenie autosomalne recesywne)
- Zespół Bernarda-Souliera – choroba spowodowana mutacją genu kodującego inny błonowy kompleks glikoproteinowy płytek GPIb, który stanowi receptor dla czynnika von Willebranda. Charakterystyczne są duże rozmiary płytek (dziedziczenie autosomalne recesywne)
Inne przyczyny trombocytopenii
- Rozcieńczenie krwi spowodowane masywnymi transfuzjami koncentratu krwinek czerwonych bez jednoczesnego podania płytek
Przyczyny podwyższonej liczby płytek
Nadpłytkowość (trombocytoza) jest zwykle spowodowana występowaniem innych chorób (nadpłytkowość wtórna lub odczynowa), takich jak:
Nowotwór, najczęściej płuc, przewodu pokarmowego, jajnika, piersi lub chłoniak
- Niedokrwistość, szczególnie z niedoboru żelaza i niedokrwistość hemolityczna
- Stan zapalny, taki jak: nieswoiste zapalne choroby jelit lub reumatoidalne zapalenie stawów
- Zakażenie, np. gruźlica
- Po chirurgicznym usunięciu śledziony
- Stosowanie doustnych środków antykoncepcyjnych.
Zwiększona liczba płytek krwi może być także zjawiskiem przejściowym. Do niektórych przyczyn należą:
- Okres zdrowienia po utracie dużej objętości krwi np. w wyniku urazu lub zabiegu chirurgicznego
- Wysiłek fizyczny
- Okres zdrowienia po zatruciu alkoholem oraz po leczeniu niedokrwistości z niedoboru witaminy B12 i kwasu foliowego.
Rzadziej trombocytoza spowodowana jest zaburzeniem czynności szpiku kostnego. Przykładem jest nadpłytkowość samoistna (pierwotna), rzadkie zaburzenie mieloproliferacyjne, w którym szpik kostny wytwarza płytki krwi w ogromnym nadmiarze. Często zaburzenie przebiega bezobjawowo, a wykrywane jest po wykonaniu badania morfologii krwi. U chorych z tym zaburzeniem z powodu zbyt dużej liczby płytek krwi występuje ryzyko nadmiernego wykrzepiania (zakrzepica), ale mogą również występować krwawienia, jeśli płytki nie działają prawidłowo. Nadpłytkowość samoistna związana jest często z mutacją genu JAK2. Znacznie zwiększoną liczbę płytek krwi obserwuje się także u chorych z innymi nowotworami i zespołami mieloproliferacyjnymi lub mielodysplastycznymi, jak na przykład przewlekła białaczka szpikowa i czerwienica prawdziwa.
Uwaga
Dla wielu oznaczeń nie ustalono standardowych zakresów referencyjnych. Ze względu na to, że wartości te zależą od wielu czynników takich jak: wiek, płeć, badana populacja, metoda oznaczenia, wyniki przedstawione jako wartości liczbowe mają różne znaczenie w różnych laboratoriach. Wynik powinien zawierać zakres referencyjny dla konkretnego oznaczenia. Lab Tests Online zaleca, aby pacjent przedyskutował wyniki testu z lekarzem. Dodatkowe informacje na temat zakresów referencyjnych są dostępne w artykule:
Przedziały referencyjne i ich znaczenie.
Co jeszcze należy wiedzieć?
Wzrost liczby płytek krwi może być spowodowany mieszkaniem na dużych wysokościach (w górach), wyczerpującymi ćwiczeniami fizycznymi, a także wysiłkiem w czasie porodu. Również przyjmowanie estrogenów oraz doustnych środków antykoncepcyjnych może spowodować zwiększenie liczby płytek krwi.
U niektórych osób występuje zjawisko gromadzenia płytek krwi w śledzionie, co powoduje spadek liczby trombocytów we krwi krążącej. Zwykle nie powoduje to jednak żadnych objawów chorobowych.
Pytania i odpowiedzi
- Czy istnieją oznaki niskiego lub wysokiego poziomu płytek krwi, na które należy zwracać uwagę?
O zbyt niskiej liczbie płytek krwi świadczyć może powstawanie siniaków bez przyczyny, krwawienie z nosa, ust lub odbytu pomimo braku widocznego uszkodzenia, lub też niemożność zatamowania przez długi czas krwawienia nawet z niewielkiej rany.
- Na wyniku badania PLT podane są wskaźniki MPV i PDW. Co one oznaczają?
Średnia objętość płytek krwi (MPV) i szerokość rozkładu objętości płytek krwi (PDW) są wskaźnikami automatycznie wyliczanymi przez analizator hematologiczny. MPV odpowiada średniej wielkości płytek w próbce krwi pacjenta, a PDW wskazuje na stopień zróżnicowania wielkości płytek. Wskaźniki te są dodatkową informacją na temat płytek krwi i mogą pomóc w określeniu przyczyny zbyt niskiej lub zbyt wysokiej liczby PLT. Płytki młode, niedawno uwolnione do krwi ze szpiku kostnego są zwykle większe niż płytki starsze, krążące we krwi przez kilka dni.
Wysoki wskaźnik MPV (duża liczba dużych „młodych” płytek krwi) u osoby z małopłytkowością oznacza, że szpik kostny może produkować płytki i uwalnia je szybko do krążenia. Niski wskaźnik MPV (duża liczba małych „starych” płytek) u osoby z małopłytkowością może wskazywać na zaburzenia wytwarzania płytek w szpiku kostnym. Prawidłowy wskaźnik PDW oznacza, że większość płytek ma w przybliżeniu jednakową wielkość. Wysoki PDW wskazuje na duże zróżnicowanie wielkości płytek, czyli równoczesne występowanie płytek małych i dużych.
W przypadku nieprawidłowego wyniku liczenia płytek krwi często wykonywane są badania dodatkowe. Niekiedy bowiem mogą powstawać zlepy płytek, co zakłóca pomiar automatyczny i prowadzi do fałszywie obniżonej liczby PLT i zwiększenia MPV. W takich sytuacjach przeprowadza się ocenę mikroskopową rozmazu krwi obwodowej, co pozwala ocenić płytki krwi w sposób bezpośredni.
- Na wyniku badania PLT umieszczono uwagę „płytki olbrzymie”. Co to oznacza?
Terminem „płytki olbrzymie” określa się płytki nieprawidłowo duże, zbliżone wielkością do erytrocytów. Mogą występować w takich schorzeniach jak pierwotna małopłytkowość immunologiczna (ITP) lub w rzadkich wrodzonych zespołach, np. chorobie Bernarda-Souliera. Aby potwierdzić występowanie płytek olbrzymich trzeba dodatkowo ocenić rozmaz krwi obwodowej, w którym można odróżnić płytki olbrzymie od zlepów płytkowych. W przypadku zlepiania się płytek krwi konieczne jest zazwyczaj pobranie próbki krwi z użyciem innego antykoagulantu, który zapobiega lub osłabia zjawisko zlepiania się trombocytów.
- Jakie badania dodatkowe może zlecić lekarz, gdy liczba płytek krwi nie jest prawidłowa?
Jeśli przyczyna zaburzenia jest niejasna i trudna do określenia na podstawie wywiadu medycznego i badania fizykalnego lekarz może zlecić badania dodatkowe.
W zależności od podejrzewanej przyczyny oraz wyników morfologii krwi i rozmazu krwi obwodowej może zostać obrany różny kierunek badań. Na przykład:
- Badania w kierunku stanów zapalnych: CRP, OB lub wykrywanie autoprzeciwciał skierowanych do antygenów płytek krwi
- Badania w kierunku zakażeń wirusowych i bakteryjnych
- Badania układu krzepnięcia: PT, aPTT, fibrynogen
- Badania w kierunku niewydolności nerek: kreatynina, eGFR
- Badania wskaźników gospodarki żelazem lub stężenia witaminy B12 i kwasu foliowego
- Badania wskaźników funkcji wątroby
- W ciężkich przypadkach o nieznanej przyczynie badanie szpiku kostnego.
Źródła
Link do polskich stron:
https://www.mp.pl/pacjent/hematologia/choroby/170467,maloplytkowosc
https://hematoonkologia.pl/info-o-chorobach/maloplytkowosc
https://www.termedia.pl/poz/Maloplytkowosc-odpowiednie-leczenie-szansa-na-aktywne-zycie-spoleczne-i-zawodowe,33518.html
https://www.mp.pl/pacjent/hematologia/choroby/170469,nadplytkowosc-samoistna
http://bip.ihit.waw.pl/nadplytkowosc-samoistna.html
http://www.czytelniamedyczna.pl/2857,nadpytkowo-samoistna.html
https://www.mp.pl/pacjent/objawy/226679,skazy-krwotoczne
https://hematoonkologia.pl/aktualnosci/news/id/3385-skazy-krwotoczne
Linki do stron obcojęzycznych:
American Society of Hematology: Blood Basics
Platelet Disorder Support Association
Platelets on the Web
MedlinePlus: Platelet Disorders
Mayo Clinic: Thrombocytopenia, Thrombocytosis
National Heart, Lung and Blood Institute: What are Thrombocythemia and Thrombocytosis?
